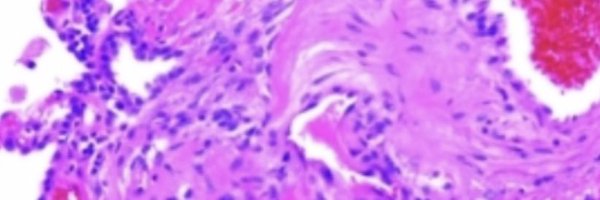
JournalClubPH Profile Banner

Pulmonary Hypertension Journal Club #PAHJC
@JournalClubPH
Followers
1K
Following
461
Media
21
Statuses
310
A new dyssynchronous Twitter Journal Club to discuss #PulmonaryHypertension articles. Account run by @AlbertaPHdoc
Joined January 2021
This is an online journal club discussion forum for for articles on the #PulmonaryCirculation and #RightVentricle. DM for suggested articles. Comment below the article. Please disclose relevant COI before posting. Welcome!
1
3
17
🎉🫁🌐 Today is #WorldPHDay2024! Join us till May 31 in raising awareness, advocating for access to PH diagnosis, treatment, and care, and celebrating lives. Let's honor the resilience of those with PH and the efforts of caregivers, researchers, doctors, and advocates. ⬇️
1
5
6
Starlink Mini offers fast, reliable internet on the go—great for traveling, camping, exploring, boating, RVing, and more. Stay connected without dead zones or slow speeds. Order online in under 2 minutes.
540
2K
10K
🙌Pulmonary hypertension patients understand the power of companionship; it elevates us beyond the limitations of PH. Our breaths are perpetually intertwined, bound not only by our shared ailment but also by a collective dream. 🫁💪⬇️
1
8
11
Today is #WorldPHDay2024 and we’re celebrating all the amazing people in our PH community who fight every day and support each other in incredible ways 💛
1
5
13
What does it really mean to live with pulmonary hypertension? Today, on #WorldPHDay2024, please share this short animation to help people understand what can be going on beneath the surface: https://t.co/Bz9Uanl3vD
#BeKind
0
8
17
Today is World PH Day! 💜 We invite you to read our new survey report, "The Socioeconomic Burden of PAH in Canada.": https://t.co/LbtJgYrqMe Learn more about World PH Day and how you can get involved at https://t.co/8B1avFbrv1.
#WPHD2024 #WorldPHDay #PHACanada #PAHSurvey
0
2
8
Namib race update: yesterday racers trekked through temperatures of around 57 degrees Celsius! Despite this, William is back up to 16th place! Keep it up Will, and please keep donating if you can: https://t.co/8SelGd0Kfo
#PulmonaryHypertension #Fundrasing #RacingthePlanet
0
2
4
Today is #WorldPHDay2024
#PulmonaryHypertension is a severe condition of the lungs and heart that can affect people of all ages, genders, and races. 🫁🫀 Find out more about it from great organizations like @PHACanada @PVRI @EuropePHA @PHA_UK @phaware
0
11
34
Another great one from the French #PAH network. In this study, the role of RHC in followup is clarified. RHC helps refine risk in intermediate but not low or high risk pts. SVI and SvO2 most useful @pulmotension @OSitbon @AthenaisBoucly @ERSpublications
https://t.co/wyOVOS5K9G
0
17
30
Genomics of CTEPH and PE. https://t.co/1dDU8Cr1Dh. New insights into CTEPH and the lack of common variants between CTEPH and PAH. Really great work! @mark_toshner
1
6
19
What does “disease modification” mean in #PulmonaryArterialHypertension? Honoured to be part of this perspective in @ATSBlueEditor led by @Viniciodjperez & @docroham
https://t.co/ICEMZLjPqY
@VApccm @BogaardHarm @mpsotka @PHACanada @PHAssociation
@PVRI @UAlberta_DoM
2
13
37
How can network meta-analyses inform treatment decisions for PAH? What are the challenges and advantages of this approach? Happy to share our editorial published in EHJ @ESC_Journals on navigating through treatments for PAH https://t.co/9fULU90XnJ
@AlbertaPHdoc @UofT_DoM
0
3
7
Deadline is approaching for this amazing opportunity for early career researchers. I owe my whole career to a generous @EuroRespSoc @CTS_SCT Long Term Research Fellowship in 2016. Apply now! @PVRI @atscommunity
https://t.co/FTZ9rqUNte
ersnet.org
Long-term research fellowships support early career scientists and clinicians to carry out projects that enhance research skills and clinical training.
0
5
15
Now hanging in the office. From a patient who wanted to dispel the notion of their lung condition being a “disease”, a word with an ugly connotation, when their lungs feel, and truly are, something beautiful 🫁#PulmonaryHypertension
#PAH
@PHACanada
@PVRI
2
3
60
Excited to share this new letter out in @ATSBlueEditor ! A cool collaboration with @PennMedPH "Win Statistics in Pulmonary Arterial Hypertension Clinical Trials" What are win statistics and what did we find out about them in #PAH? A 🧵 https://t.co/WKfxck03ss
1
12
42
What’s in the pipeline for disease modification approaches in #PAH? Targeting epigenetic modification may a path forward in the future. Fascinating talk from @PullamsettiL
#ERS2023 #ERSCongress
@ErsPvd @sbonnet2
0
12
32
Dr Marius Hoeper provides an update on #sotatercept. Is it a disease modifying agent? Where will it fit in the treatment algorithm? #ERS2023 #ERSCongress @ErsPvd @EuroRespSoc
0
14
34
Are our existing #PAH therapies disease modifying? Maybe, probably. Masterful talk by my friend and mentor @OSitbon
#ERS2023 #ERSCongress
0
14
40
Hoping to retain my Top 10 ERS influencer title this year. Will aim to share all the exciting #PulmonaryHypertension data with you as it comes! #ERSCongress #ERS2023
6
9
95
First results of #sotatercept from the open label extension #SOTERIA study. #ERSCongress #ERS2023 Stable improvements, few serious treatment emergent adverse events, maybe further improvement in low risk% 8 patients got off prostacyclin
1
22
50
Interesting #seralutinib imaging substudy of #TORREY phase 2 trial, showing improvement in BV5A/BV10A. Suggests reverse remodeling? Correlated with improvement in stroke volume and PCa. #ERSCongress #ERS2023 @ErsPvd
#PulmonaryHypertension
0
15
41